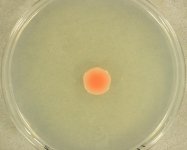

<< back to search
IMAGES:



Search Details
add to cart
| UAMH Number: | 7169 |
|---|---|
| Species Name: | Rhodotorula sp. |
| Type: | |
| Synonyms: | Chromotorula / Rhodosporidium |
| Taxonomy: | FUNGI Basidiomycota, Microbotryomycetes, Sporidiobolales, Sporidiobolaceae |
| Strain History: | S.P. Abbott (SA-M255) -> UAMH |
| Substrate: | indoor air of office, RCS strip | Location: | CANADA Alberta, Fort McMurray (GEO: 56.726,-111.38) |
| Isolator: | S.P. Abbott (SA-M255) |
| Isolation Date: | 1992-04-23 |
| Date Received: | 1992-06-25 |
| Characters: | CULTURE CONDITIONS API ID 32 C profile # 5461640111 // CULTURE CONDITIONS API profile # 2640073 // THERMOTOLERANT grows @ 35 C |
| Compounds: | |
| Cross Reference: | |
| Pathogenic Potential: | Human: yes | Animal: yes | Plant: no |
| Biosafety Risk Group: | RG2 (check the PHAC ePATHogen Risk Group Database for updates) |
| Regulatory Requirements: | Canadian requesters must provide PHAC Pathogen and Toxin License Number (see: https://www.canada.ca/en/public-health/services/laboratory-biosafety-biosecurity/licensing-program.html) prior to shipment. International requesters must provide all legally required importation documentation prior to shipment. Plant pathogenicity status may be verified by using the USDA Agricultural Research Service (ARS) Fungal Database |
| MycoBank ID: | 9741 |
IMAGES: